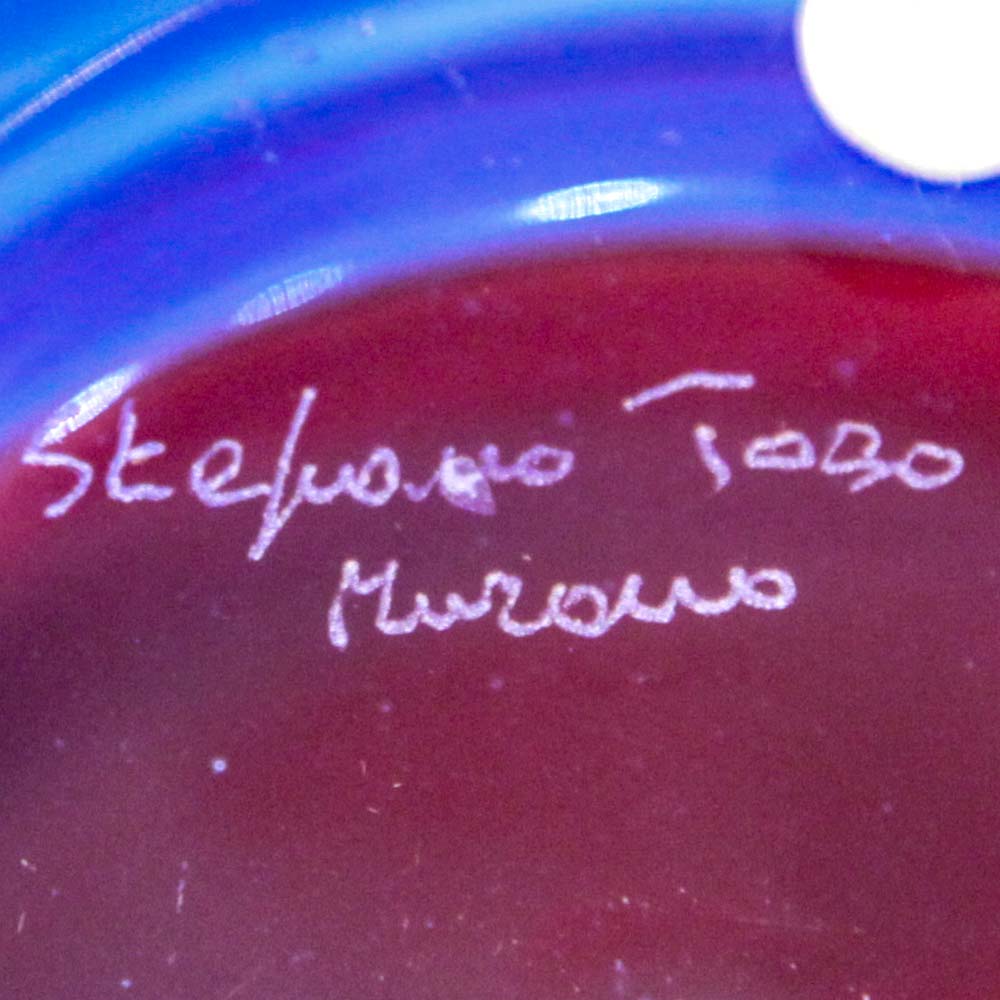

Sedimenti Collection - Blue & Red Vase
Dimensions
- Height: 19cm - 7.48"
- Width: 26cm - 10.24"
- Depth: 26cm - 10.24"
Availability: 1 in stock
The "Sedimenti Collection" has been created in the 90's by the maestro Romano Donà in partnership with Stefano Toso. The incalmo technique joins its maximum expression in this collection of vases: it is executed 4 times on each piece to achieve perfection. The results speak for themselves: uniqueness in beauty of colours and design.
Designed by Stefano Toso, handmade in Murano by Romano Donà following the ancient Muranese techniques.
Shipping
Free shipping on orders over €40 - to US, EU and Canada
Customer service
We are available 24/7 to answer your questions.
Contact us: info@muranonet.com
Secure payment
Your payment information is processed securely.


The Essence of Murano Glass
MuranoNet represents excellence in Murano glass craftsmanship, an art passed down through generations. Our brand blends tradition and innovation, offering unique, handmade pieces by Murano master glassmakers. Each creation tells a story of passion, dedication, and skill, reflecting the timeless beauty and elegance of genuine Murano glass. Choosing MuranoNet means bringing home a piece of history, an authentic and refined work of art, capable of enriching any space with its extraordinary luminosity and sophistication.

 MuranoVitrum Guarantee
MuranoVitrum Guarantee